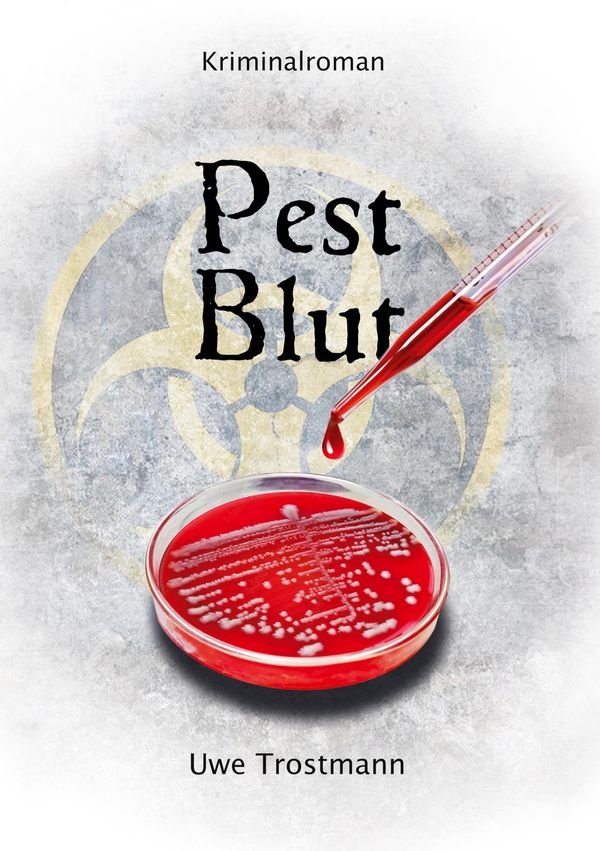
Pest Blut - Uwe Trostmann (Buch)

ISO 4017 Sechskantschraube VG M6x10 Edelstahl A2 blank ; Industrial Quality Supplies
€9.98
inkl. MwSt. zzgl. Versand
Versand: €5.95

Grundfos Blockpumpen elektr. geregelt NBGE 150-125-400/345AASF2AESBQQESW3
€22,116.99
inkl. MwSt. zzgl. Versand
Versand: €0.00

Kubala Edelstahlspachtel 140Mm 0572
€10.99
inkl. MwSt. zzgl. Versand
Versand: €0.00

Hoesch Glasverkleidung weiß, für 3708, für freistehend
€2,902.99
inkl. MwSt. zzgl. Versand
Versand: €0.00

Hacker im Spiegel des Völkerrechts
€39.00
inkl. MwSt. zzgl. Versand
Versand: €0.00

Hydraulikpumpe - 550105696
€375.77
inkl. MwSt. zzgl. Versand

LED Kopfteil mit Ablagen Schwarz Eiche 100x18,5x103,5 cm, Kopfteile DesignMöbel Neu
€53.59
inkl. MwSt. zzgl. Versand
Versand: €29.99

Horseware Outdoordecke Rambo Optimo Plus Turnout Bundle, 0 g + 200 g, mit abnehmbarem Halsteil
€479.95
inkl. MwSt. zzgl. Versand
Versand: €0.00

Spannbild ️ Türkisfarbenes Meer | Quadrat | wandbild.com 200 x 200 / Rahmen als Bausatz
€694.00
inkl. MwSt. zzgl. Versand

SKF Spurstangenkopf VKDY 316057
€18.09
inkl. MwSt. zzgl. Versand

Poster "FRÜHER I Grau" artboxONE - Typografie,Menschen,Lehrersprüche,Für Papa,Lustig
€9.99
inkl. MwSt. zzgl. Versand
Versand: €4.99

Du bist WERTVOLL
€3.95
inkl. MwSt. zzgl. Versand
Versand: €3.90

Blumen - Linien Wandtattoo in 6 Größen - Wandaufkleber Wall Sticker - Dekoration, Küche, Wohnzimmer, Schlafzimmer, Badezimmer
€24.99
inkl. MwSt. zzgl. Versand
Versand: €6.90

Alu-Dibond "Hamburg Max-Herz-Ring, Sommer,low" 30x30 cm artboxONE
€69.99
inkl. MwSt. zzgl. Versand
Versand: €4.99

Schoenenberger Naturreiner Heilpflanzensaft Salbei 200 ml
€9.79(€48.95 / l)
inkl. MwSt. zzgl. Versand

Fernbedienung passend für INNO IH19820DVD-IDTV
€16.95
inkl. MwSt. zzgl. Versand
Versand: €0.00

Sanipa Waschtischunterschrank „3way“ 550 × 588 × 447 mm in Wine-Red
€605.42
inkl. MwSt. zzgl. Versand
Versand: €69.00

Pikeur Damen Shirts Function Zip Shirt white Selection FS 2026, Größe:40
€69.95
inkl. MwSt. zzgl. Versand
Versand: €0.00

Wechselmotiv ️ Gipfel in den Alpen | Hochformat | wandbild.com 150 x 200
€179.00
inkl. MwSt. zzgl. Versand

Tischläufer Potato Print Dots - Symbole & Muster - von „Studio Kesse"; minimal, Punkte, skandinavisch, Geometrisch, Hygge, M...
€27.95
inkl. MwSt. zzgl. Versand
Versand: €5.95

Herren Grafik T-Shirt Direkt aus Vientiane – Straight Outta Vientiane – Öko-Verantwortlich Vintage Jahrgang Kurzarm Lustige Druck Geburtstag G...
€22.95
inkl. MwSt. zzgl. Versand
Versand: €4.95

sweeek - Rechteckiger Sonnenschirm 2x3m - Sand
€59.99
inkl. MwSt. zzgl. Versand
Versand: €9.99

Was bitte schön ist Burnout?
€24.90
inkl. MwSt. zzgl. Versand
Versand: €0.00

1 Staubsaugerbeutel (zum Testen) für Progress - M302, M301, M311, Progress - PC 2260, Progress - PA 17, Progress - Onyx 122, Progress - PC 2265, P...
€3.36
inkl. MwSt. zzgl. Versand
Versand: €0.00

Schreibtisch Kufe Einzels. Quadrat B2000xT900xH650-850 ws/Weiß
€590.17
inkl. MwSt. zzgl. Versand
Versand: €0.00

Herren Grafik T-Shirt Zeit dem Sommer in Balabac Hallo zu sagen – Time To Say Hello To Summer In Balabac – Öko-Verantwortlich Vintage Jahrgang...
€24.95
inkl. MwSt. zzgl. Versand
Versand: €4.95

DIN 965 Form CE Senkkopfschraube M6x16 Edelstahl A4 blank T30 ; Industrial Quality Supplies
€11.19
inkl. MwSt. zzgl. Versand
Versand: €5.95

Zip-Off Hose Klättermusen Jorid Zip Off Pants Herren (Gr M |grün)
€249.95
inkl. MwSt. zzgl. Versand
Versand: €0.00

Wenn der Apfellastwagen kommt - Margit Weiss, Audio, 9788872838976
€19.99
inkl. MwSt. zzgl. Versand
Versand: €0.00

MB Design Felgen VR3 7.5Jx18 ET 33 5x100 Diamant Silber 4-VR37518335AZ-CH1 kompatibel mit Subaru BRZ Impreza
€1,764.43
inkl. MwSt. zzgl. Versand
Versand: €0.00
Flaschenhalter für CO2 Flasche 2 kg
€10.86
inkl. MwSt. zzgl. Versand
Versand: €5.94
Pest Blut - Uwe Trostmann (Buch)
€14.00
inkl. MwSt. zzgl. Versand
Versand: €0.00

Caprice stiefel Stiefelette schwarz in Gr. 36.5
€78.95
inkl. MwSt. zzgl. Versand
Versand: €0.00

ProjektX Schuhschrank 4 Schubladen 2 Klapptüren weiß Hochglanz.
€297.18
inkl. MwSt. zzgl. Versand
Versand: €0.00

Herren Grafik T-Shirt Motorradfahrer neuer Stil seit 1951 – Motorcycle Riders Since 1951 – Geschenk 73. Geburtstag Jahrestag 73 Jahre
€20.95
inkl. MwSt. zzgl. Versand
Versand: €4.95

PUMA Sportnadrágok 'Strong' Női fekete , Méret M
HUF 13,990.00
inkl. MwSt. zzgl. Versand

PET-flaska 750ml med avgasande skruvkork röd
SEK 28.00
inkl. MwSt. zzgl. Versand

Herren Grafik T-Shirt Bedarf ist der Schlüssel – Need Is The Key – Öko-Verantwortlich Vintage Jahrgang Kurzarm Lustige Druck Geburtstag Gesch...
€24.95
inkl. MwSt. zzgl. Versand
Versand: €4.95

Werzalit Fensterbank Compact S18 Polarweiß - Perlstruktur, Tiefe: 250 mm x Länge: 2200 mm mit Kunststoffabschluss
€124.28
inkl. MwSt. zzgl. Versand
Versand: €6.99

Herren Grafik T-Shirt Ich war in Athen aber die Grafiken waren nicht gut – I Went To Athens But The Graphics Weren’t Good – Öko-Verantwortli...
€20.95
inkl. MwSt. zzgl. Versand
Versand: €4.95

Magdalena und Albin - Landwirte auf Aspeberget
€11.90
inkl. MwSt. zzgl. Versand
Versand: €2.90

LASCANA String toffee Gr. 40/42 für Damen
€25.99
inkl. MwSt. zzgl. Versand
Versand: €4.95

Erzählungen 2: In Einfacher Sprache - Edgar Allan Poe (Buch)
€12.99
inkl. MwSt. zzgl. Versand
Versand: €0.00

Küchenteppich 60x240cm rutschfest & abwischbar PVC Läufer - Gealterte Wandoberfläche
€89.00
inkl. MwSt. zzgl. Versand
Versand: €0.00

Claris FileMaker Annual User NPO/EDU 4 Jahre Neukauf Tier 1 (5 - 9 Seats)
€527.95
inkl. MwSt. zzgl. Versand
Versand: €0.00

Wallario 9 Stück breite Ordner inkl. Klebeetiketten mit Motive Lustiger Frosch in grün und orange - Set mit Rückenschildern / Ordnerrücken Sti...
€49.95
inkl. MwSt. zzgl. Versand
Versand: €6.99

MuchoWow - Wierderverwendbar - Selbstklebend
€18.95
inkl. MwSt. zzgl. Versand
Versand: €0.00

MuchoWow Laptop Aufkleber Sticker Cover Kaktus - Grün - Pflanze - Natur 30x22 cm - Laptop-Sticker
€18.99
inkl. MwSt. zzgl. Versand
Versand: €0.00

Marc O'Polo MARC O POLO Damen Bluse 36/S Mehrfarbig Grafisch Casual Vintage Baumwolle Gr. 36 Damen
€8.95
inkl. MwSt. zzgl. Versand
Versand: €0.00

FEBI BILSTEIN 42333 - OE GJ6A 34 156 Stabigummis für 6 (G)
€9.00
inkl. MwSt. zzgl. Versand
Versand: €10.00

HELLA Wischblatt - 9XW 178 878-241 - 9XW178878241
€9.06(€4,530.00 / ct)
inkl. MwSt. zzgl. Versand

vhbw Ölfilter kompatibel mit BMW 3er 2002/06-2005/02 E46 316i 1596 ccm 85 KW 115 PS KFZ
€9.09
inkl. MwSt. zzgl. Versand
Versand: €0.00

100 Experimente mit Gott, Taschenbuch von Susanne Niemeyer, Herder, 978-3-451-03102-1
€14.00
inkl. MwSt. zzgl. Versand
Versand: €0.00

Herren Grafik T-Shirt Zürcher Lebensstil – Zurich Lifestyle – Öko-Verantwortlich Vintage Jahrgang Kurzarm Lustige Druck Geburtstag Geschenk Mann
€17.95
inkl. MwSt. zzgl. Versand
Versand: €4.95

MuchoWow Wandtattoo Wandsticker Wandaufkleber Panther - Wald - Augen 60x120 cm Selbstklebend und Repositionierbar - Selbstklebend - Fototapeten
€38.99
inkl. MwSt. zzgl. Versand
Versand: €0.00

The Diamond Mirror - Lewis Sylvester Hough (Buch)
€14.90
inkl. MwSt. zzgl. Versand
Versand: €0.00

Ecco S-Three BOA Ombre/Sand 40 Herren Golfschuhe
€236.99
inkl. MwSt. zzgl. Versand
Versand: €0.00

Tommy Jeans Farmer 'THEO' Férfi kék , Méret 34
HUF 31,990.00
inkl. MwSt. zzgl. Versand

TSC Thermotransferband, Premium Wachs/Harz, Rollenbreite: 110mm, Kern: 25,4mm, Länge 625m
€189.21
inkl. MwSt. zzgl. Versand
Versand: €9.52

Akku für Laptop Lenovo ThinkBook 15 G2 ITL 20VE005GAD
€49.90
inkl. MwSt. zzgl. Versand
Versand: €0.00

hansgrohe Kopfbrause Axor m Arm, ek Ro, 460x300mm, 2jet, b bla vc
€3,433.99
inkl. MwSt. zzgl. Versand
Versand: €0.00

Williot Kardigán Női rózsaszín , Méret XL
HUF 29,635.00
inkl. MwSt. zzgl. Versand

Malschablone für Handwerk A5 15x21cm, Rose Blume Natur Muster, Wiederverwendbare Kunststoff DIY & Scrapbooking Zeichenschablone
€10.90
inkl. MwSt. zzgl. Versand
Versand: €6.50

Sons of Arthrose Ibuprofen Chapter Biker Motorrad Opa Geschenk Uni Hoodie Kapuzenpullover, Schwarz, M
€39.95
inkl. MwSt. zzgl. Versand
Versand: €0.00

MuchoWow Laptop Aufkleber Sticker Cover Wolf - Braun - Wald 25x18 cm - Laptop-Deko
€12.95
inkl. MwSt. zzgl. Versand
Versand: €0.00

CALVENDO Puzzle Flosse frei fürs Abenteuer | 1000 Teile Lege-Größe 64x48cm Foto-Puzzle für glückliche Stunden
€33.99
inkl. MwSt. zzgl. Versand
Versand: €0.00

2 Teile/satz Frauen Bikini Set Neckholder Gepolsterter BH Hohe Taille Badehose Set Farbverlauf Split Bademode
€16.59
inkl. MwSt. zzgl. Versand
Versand: €0.00

Highboard Grau Sonoma 34,5x34x180 cm Holzwerkstoff
€131.52
inkl. MwSt. zzgl. Versand
Versand: €0.00

Leinwandbild Modern Pop - Gerard Madau - Surrealoft, Frida Pop & Gorilla – 120x90 cm
€269.00
inkl. MwSt. zzgl. Versand
Versand: €0.00

Dachbox VDP Satellite 330 + Dachträger Original Stahl kompatibel mit Mazda 2 III 5 Türer ab 2015
€374.95
inkl. MwSt. zzgl. Versand
Versand: €4.95

MuchoWow Textilposter Blumen - Collage - Kunst 120x120 cm mit holzfarbenen Rahmen - Textil-Poster
€50.95
inkl. MwSt. zzgl. Versand
Versand: €0.00

Friends Like These Körömcipők Női bézs , Méret 4
HUF 27,275.00
inkl. MwSt. zzgl. Versand

Stoßdämpfer Magneti Marelli vorne links 52036184
€80.49
inkl. MwSt. zzgl. Versand
Versand: €15.00

KOTARBAU Einsteckschloss 90/22 BB Gegenplatte Verzinkt Universal Links/Rechts Rohrrahmenschloss Zimmertürschloss Innen/Außenbereich Sicherheiss...
€18.18
inkl. MwSt. zzgl. Versand
Versand: €5.99

Neosens Absatzschuhe Damen S576 RESTORED SKIN EBONY / DEBINA Farbe Schwarz
€100.97
inkl. MwSt. zzgl. Versand
Versand: €0.00

Werbeartikel Schoko-Eier 6er-Set mit Lindt Schoko-Eier, Klimaneutral, FSC – mit Logo bedruckt
€2.49
inkl. MwSt. zzgl. Versand
Versand: €6.90

Herren Grafik T-Shirt Original Vintage-Kleidung seit 1968 – Original Vintage Clothing Since 1968 – Geschenk 56. Geburtstag Jahrestag 56 Jahre J...
€20.95
inkl. MwSt. zzgl. Versand
Versand: €4.95

Kariban Herren Softshell Jacke wasserabweisend Softshelljacke, Größe:L, Farbe:Rot
€49.26
inkl. MwSt. zzgl. Versand
Versand: €4.50

Spiralbohrer DIN 1897 TypN A120 D.8.2mm HSS dampf.Zyl.schaft 2.5 Rechts DORMER
€117.89
inkl. MwSt. zzgl. Versand
Versand: €0.00

BOSCH 1 987 949 090 Zahnriemen für FORD FIESTA III (GFJ) 1248mm 131-Zähne
€12.56
inkl. MwSt. zzgl. Versand
Versand: €7.10

Poster mit Rahmen schwarz "Venecian Channel" artboxONE - Städte,Reise,Architektur,Städte / Venedig
€54.99
inkl. MwSt. zzgl. Versand
Versand: €4.99

Artfilia Subtle Impressions No. 2 Variante 1 30x45 cm
€14.50
inkl. MwSt. zzgl. Versand

Falco Marshall Motorradstiefel (Brown,44)
€234.99
inkl. MwSt. zzgl. Versand
Versand: €0.00

L'Oréal Men Expert Invincible Man Antiperspirant Deodorant Spray 150ml
€5.90
inkl. MwSt. zzgl. Versand
Versand: €3.99

SAINT TROPEZ Rock 'Mila' Damen Größe 34 schwarz
€39.96
inkl. MwSt. zzgl. Versand
Versand: €0.00

MuchoWow Gartenposter Outdoor-Poster Rund Tisch - Stilleben - Schwarz - Weiß Ø 90 cm Gartendeko Rundes Poster draußen
€49.95
inkl. MwSt. zzgl. Versand
Versand: €0.00

iPad Pro M5 - 11 Zoll - Wi-Fi - 2 TB - Nanostrukturiertes Glas - Space Schwarz
€2,626.00
inkl. MwSt. zzgl. Versand
GG–AVersand: €4.90

Jumbo Tonerkartusche für Samsung ML 2010L ML2010D3 ELS
€14.95
inkl. MwSt. zzgl. Versand
Versand: €3.90

Joma Handballtrikot STRONG TRIKOT
€22.90
inkl. MwSt. zzgl. Versand
Versand: €4.90

Garden Hero 8tlg. Gartenwerkzeug-Set in Grün - 36% | Gartendekoration
€39.56
inkl. MwSt. zzgl. Versand
Versand: €4.95
vidaXL 13-tlg. Garten-Essgruppe mit Auflagen Poly Rattan Braun
€929.00
inkl. MwSt. zzgl. Versand
Versand: €0.00

Huuraa Baumwollbeutel Rose Geschenk Einkaufstasche Natural 10 Liter Baumwolle Rose Accessoire
€14.99
inkl. MwSt. zzgl. Versand
Versand: €0.00

TRUCKTEC Spurstangenkopf 22.37.006 - 2237006 passend für LR026267
€25.61
inkl. MwSt. zzgl. Versand

MuchoWow Textilposter Elefant - Tiere - Bäume - Natur 120x160 cm mit schwarzem Rahmen - Magnetischer
€59.95
inkl. MwSt. zzgl. Versand
Versand: €0.00

INF HDMI Verlängerungskabel: PVC, Sauerstofffreies Kupfer, 4K, 60Hz 1 m
€14.99
inkl. MwSt. zzgl. Versand
Versand: €0.00

Herren Kapuzenpullover Quad Keine Grenzen
€39.99
inkl. MwSt. zzgl. Versand
Versand: €4.90

Glasbild Lovely Lavender III 30x30 cm
€16.95
inkl. MwSt. zzgl. Versand
Versand: €5.70

Stainless Steel Wire Rope black Set 1
€14.00
inkl. MwSt. zzgl. Versand

Tankschutzfolie Tankpad passend für Royal Enfield Meteor 350 (2021+)
€34.95
inkl. MwSt. zzgl. Versand
Versand: €0.00

Hilf Dir selbst! Teil-Fasten mit Basischer Kost, Taschenbuch von Doris Wroblewski, BoD – Books on Demand, 9783837092288
€19.80
inkl. MwSt. zzgl. Versand
Versand: €0.00


